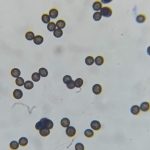

| الاسم العلمي Scientific Name | Physarum cinereum |
|---|---|
| التصنيف Classification | Physaraceae/Myxogastria |
| المكان Location | ريف شمالي مصياف / حماه |
| التاريخ Date | 20251225 |
| المصور Photographer | عدي سلوم |
| المعرف Identifier | عدي سلوم |
| الاسم الشائع Common Name | |
| المصدر Source | |
| ملاحظات Remarks | أول تسجيل لهذا العفن المخاطي slime mold في سوريا |